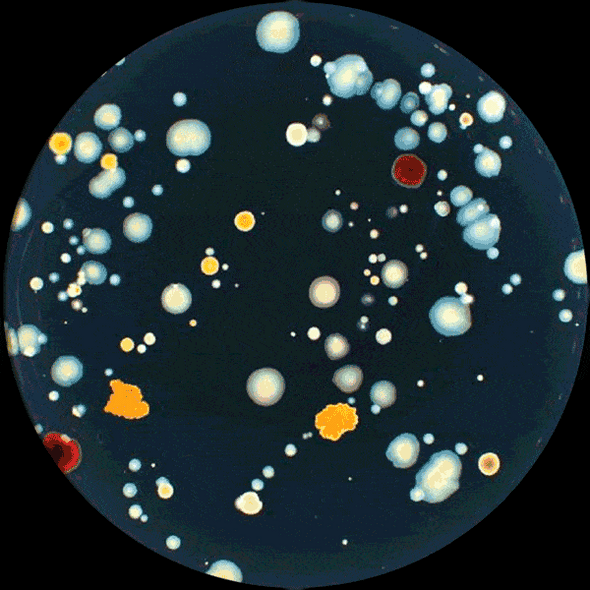
Plates Certified Validation For Counter and Reader Set of 3

Featured
-


Hygiena™ AllerFlow Swab Specific Gluten Residue Kit Pk 25
Hygiena
£240.00Hygiena™ AllerFlow Gluten is a rapid and convenient test for the detection of gluten residue on surfaces as part of an allergen monitoring program. Combining Hygiena's convenient sample collection...ALFGL25 -


Hygiena™ EnSURE Touch™ Luminometer System
Hygiena
£1,710.00EnSURE™ Touch is the next-generation quality monitoring system. It provides rapid and accurate sanitation verification to support your FSMA program. Featuring a 5-inch touch screen, wireless sync...ETOUCH -


Biodegradable Nitrile Latex/Powder Free Gloves X-Large Pk 100
£10.30Degrading only after disposal, this high quality, innovative biodegradable nitrile,(BDG) disposable, single use glove is the top choice for applications that require a non sterile protective glove...BioGloveXL -


Biodegradable Nitrile Latex/Powder Free Gloves Large Pk 100
£10.30Degrading only after disposal, this high quality, innovative biodegradable nitrile,(BDG) disposable, single use glove is the top choice for applications that require a non sterile protective glove...BioGloveL
Top Categories
Featured
Bestselling
New
Recent Posts
-
Sustainable Cooling Incubators for Testing and Diagnostics — With UK based Manufacturer LMS
Across food safety, water quality, contract testing, clinical diagnostics or indeed research, coole …13th Jan 2026 -
Meet Claire Hill, Our Clinical Diagnostics Sales Manager
If you haven't already heard the news, we're delighted to tell you that Claire Hill has joined Trafa …22nd Jan 2024 -
30 Years of Trafalgar Scientific
Today, the 16th of November, marks a significant milestone for us here at Trafalgar Scientific: it's …16th Nov 2023